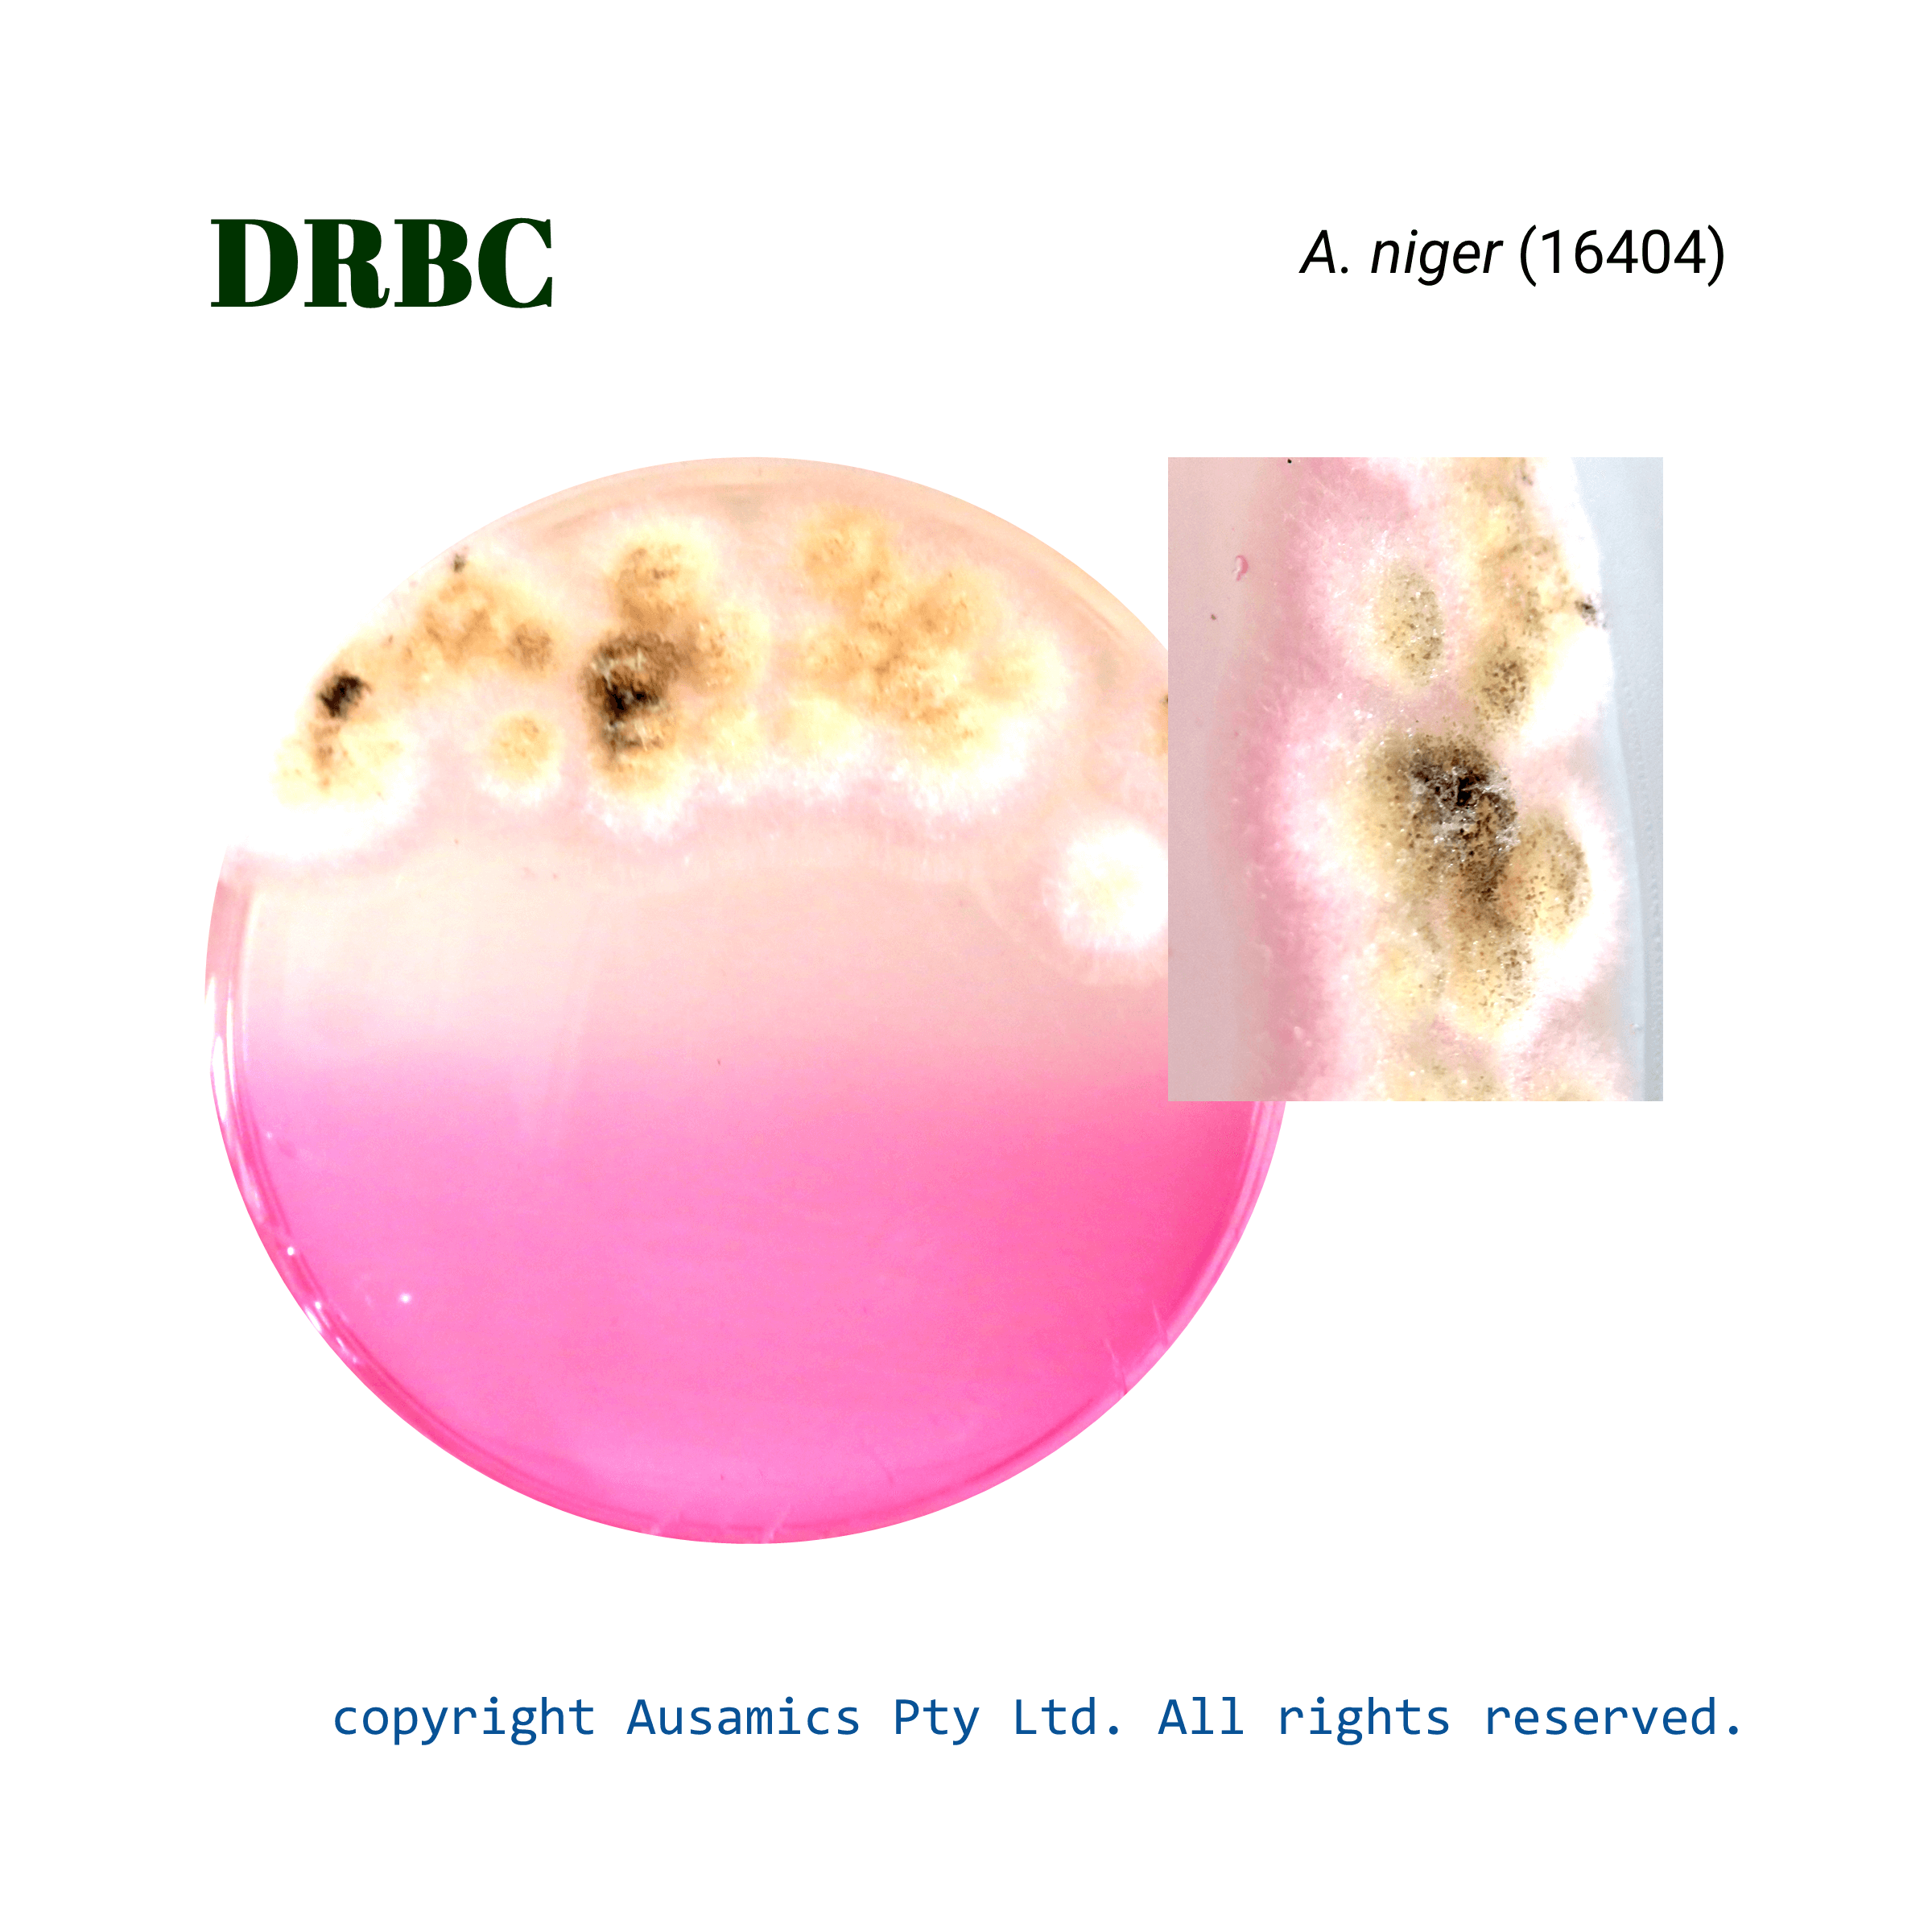
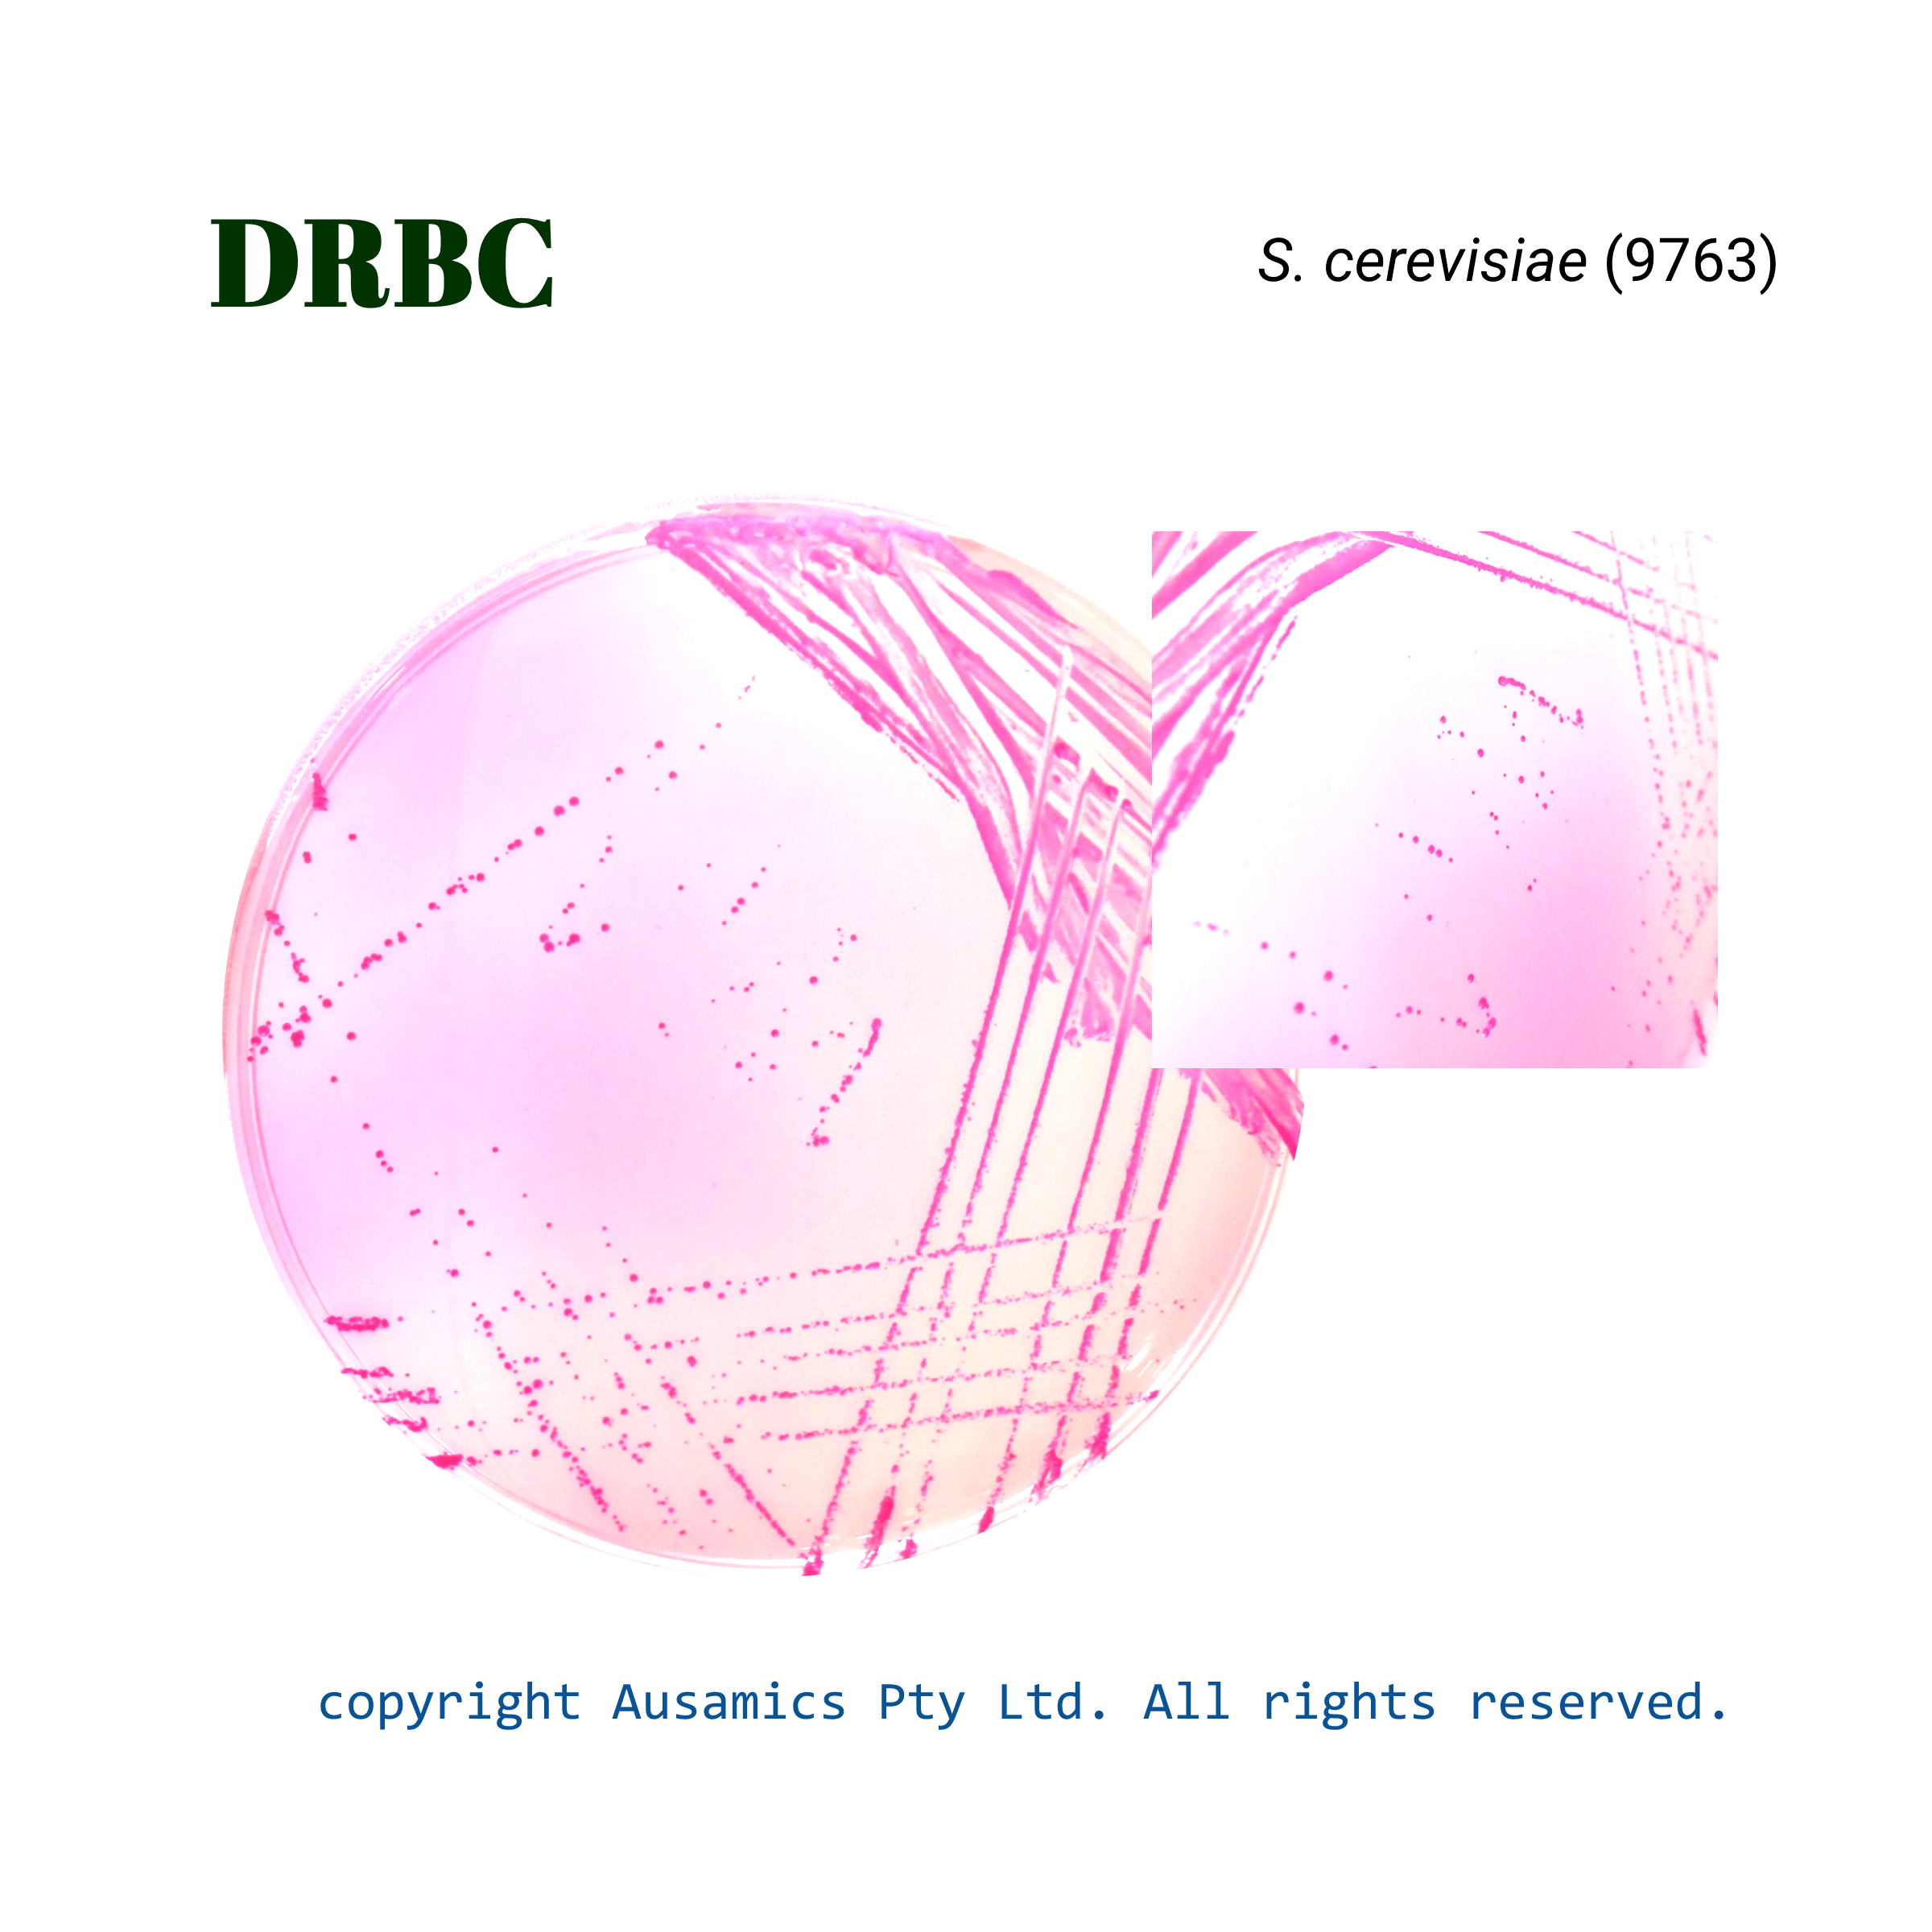
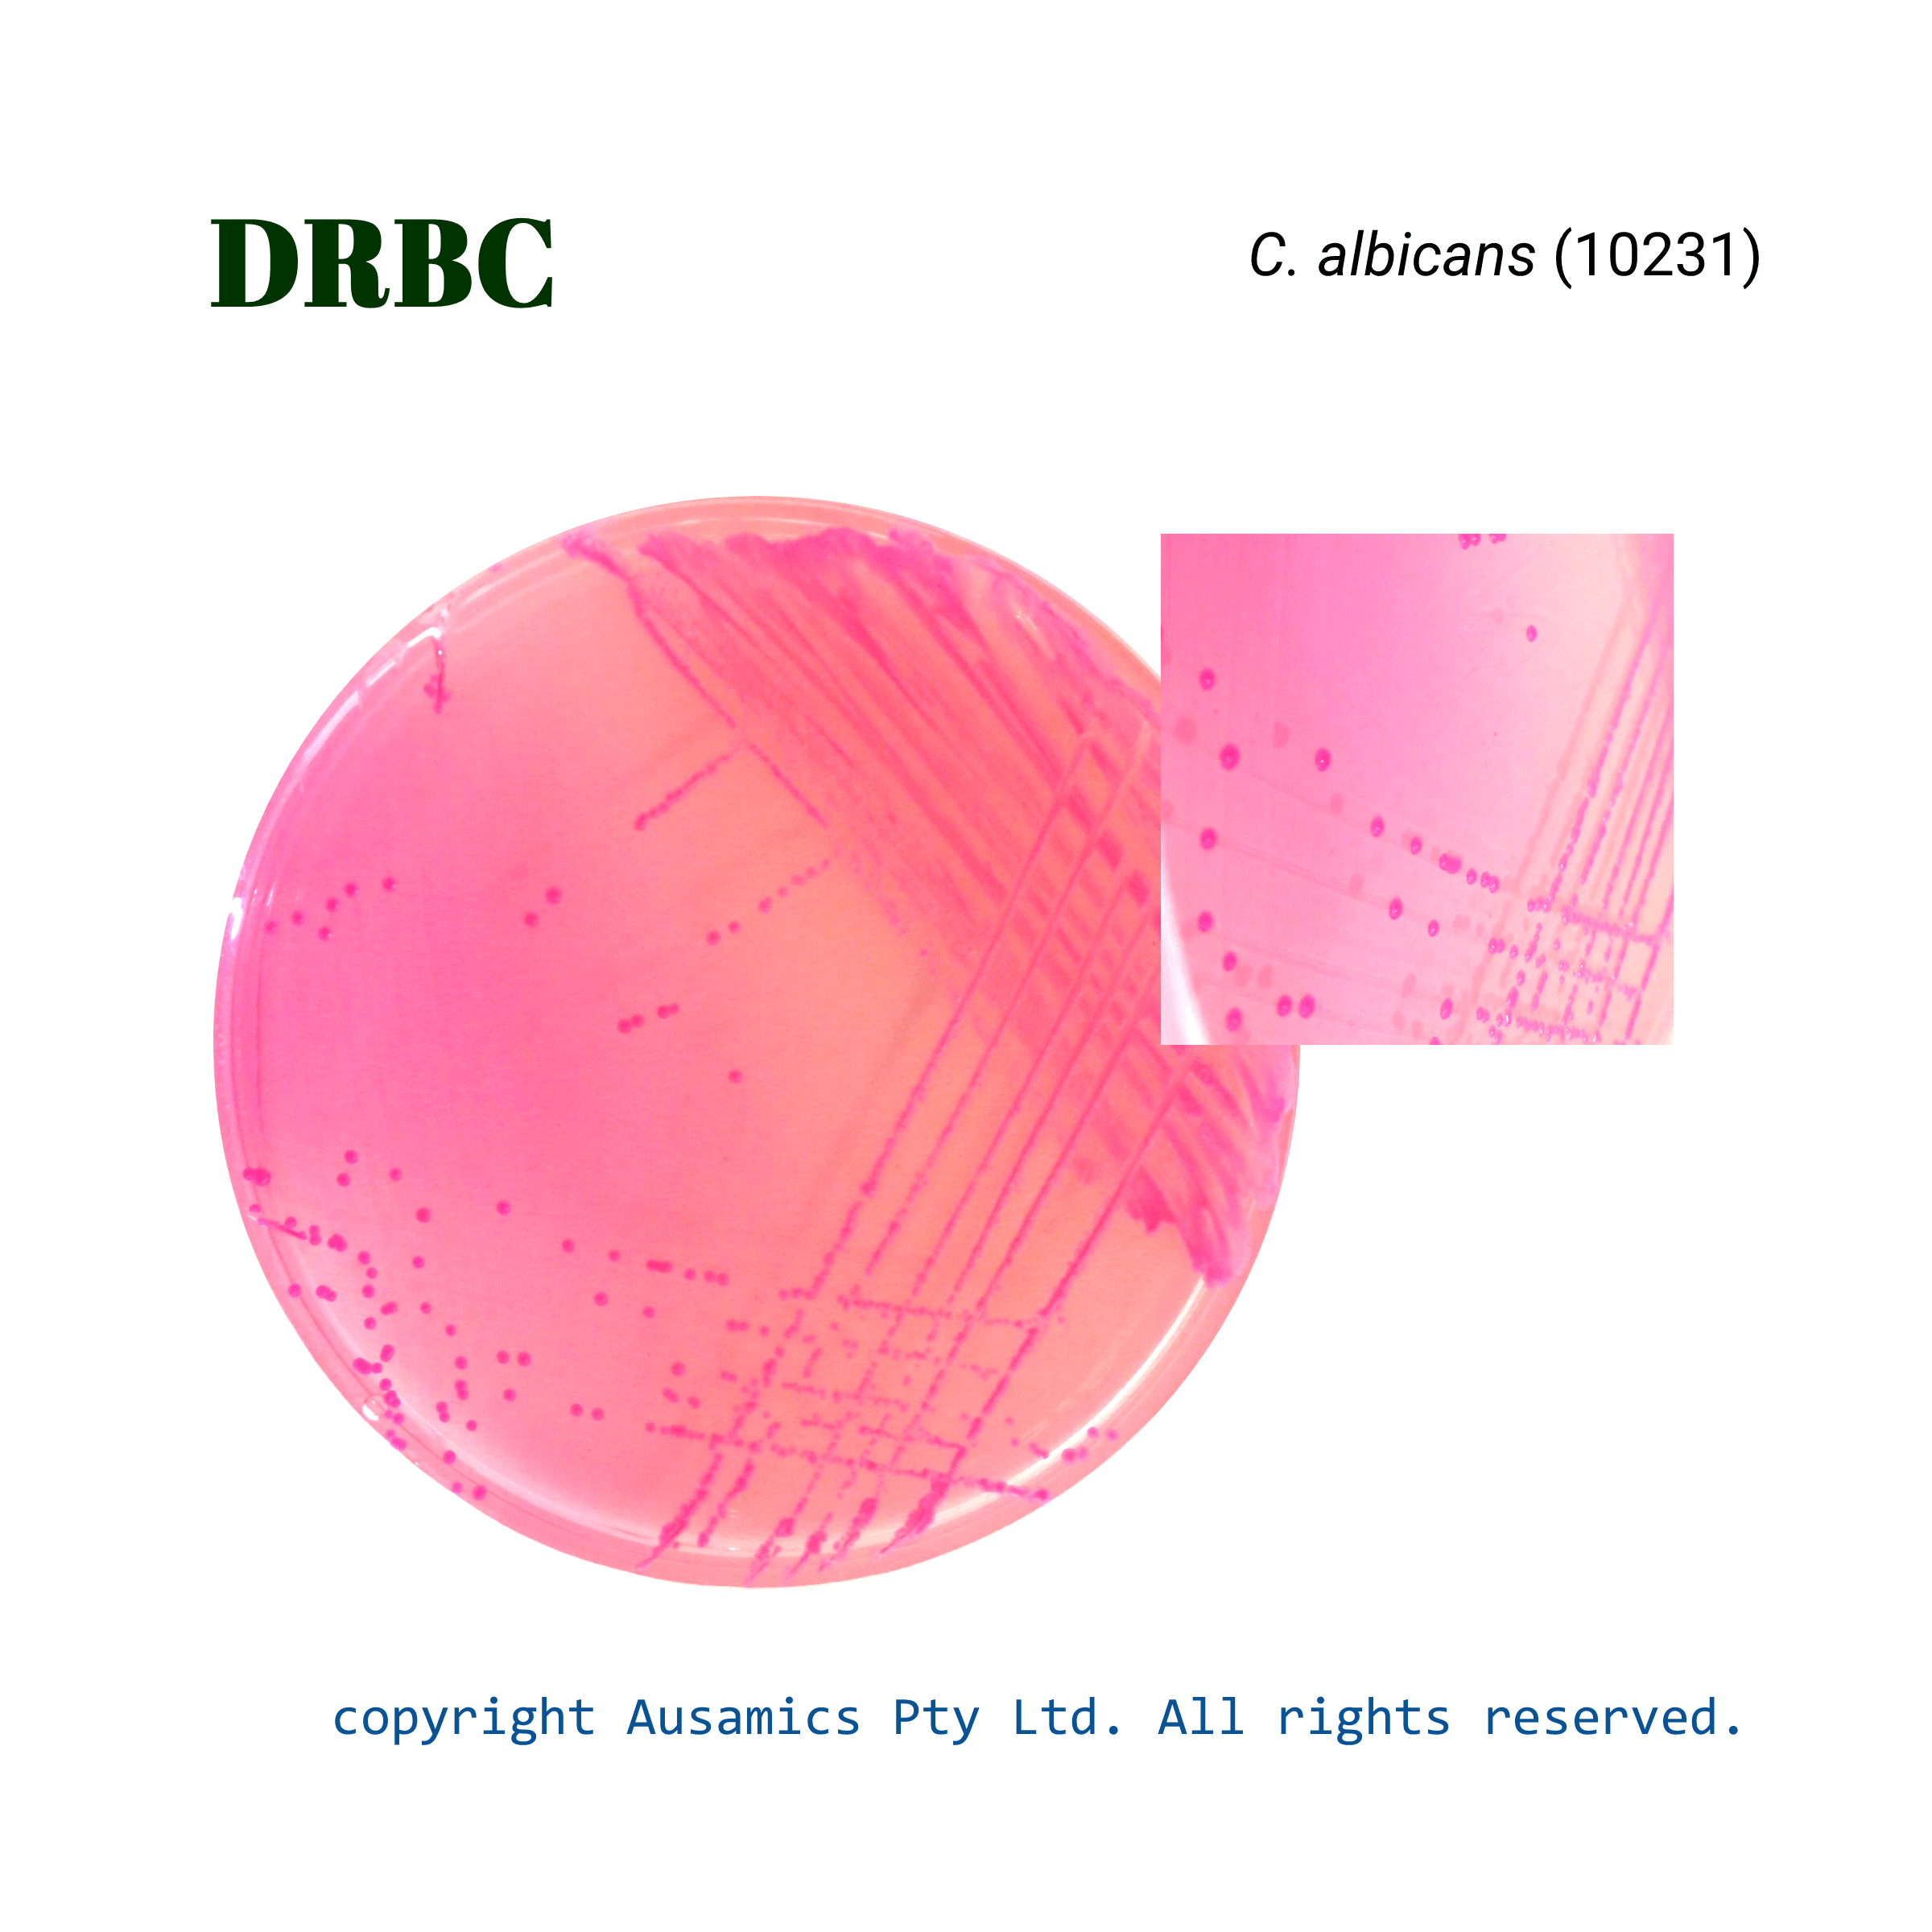

Dichloran-Rose Bengal Chloramphenicol Agar, DRBC
Dichloran-Rose Bengal Chloramphenicol Agar, DRBC Agar is used for isolation and counting of yeasts and molds in food.
- Description
- Composition
- Quality Control
- Microbial Test Results
Dichloran Rose Bengal Chloramphenicol (DRBC) Agar is a selective culture medium designed to isolate and count yeasts and molds, especially in food samples. It is a variation of Rose Bengal Chloramphenicol Agar, adding dichloran to further inhibit fungal growth. The medium comprises peptone as a nitrogen source, dextrose as a carbon source, phosphate buffer, magnesium sulfate, and the selective agents dichloran and chloramphenicol and Rose Bengal. The acidic pH (5.6) favors yeast and mold growth while inhibiting many bacteria. The medium’s composition encourages distinct colony morphology, making counting easier.
Storage
Keep the container at 15-30 °C and prepared medium at 2-8 °C.
| Composition | gr/L |
| Peptone | 5 |
| Glucose | 10 |
| Potassium Dihydrogen Phosphate | 1 |
| Dichloran | 0.002 |
| Magnesium Sulfate | 0.5 |
| Rose Bengal | 0.025 |
| Chloramphenicol | 0.1 |
| Agar | 15 |
| Final pH at 25°C | 5.6 ± 0.2 |
| Dehydrated Appearance | Pink, free-flowing, homogeneous. |
| Prepared Appearance | Light to medium amber, clear to slightly opalescent. |
| Reaction of 3.16% Solution at 25°C | pH 5.6 ± 0.2 |
| Incubate at 25±2 °C for up to 5 days. Spot inoculate for A. niger. | |
| Organism (ATCC) | Recovery |
| Saccharomyces cerevisiae (9763) | Good |
| Aspergillus niger (1015) | Good |
| Candida albicans (10231) | Good |
| Escherichia coli (25922) | None |
| Bacillus subtilis (6633) | None |